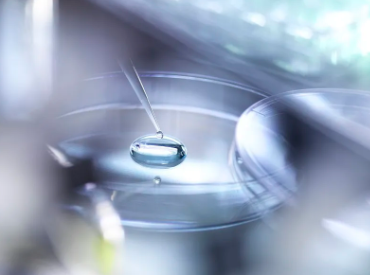
image.png

幹細胞腎髒移植費用詳情及流程解析?
2024-11-03 10:40:58 來源: 小編 咨詢醫生
幹細胞腎髒移植是一種利用患者自身或供體的幹細胞修複受損腎髒功能的方法。近年來,這一技術在我國得到了快速發展,吸引了衆多患者的關注。下面我們就來了解一下幹細胞腎髒移植的費用詳情及流程。
一、幹細胞腎髒移植費用詳情
1.初診費用:初診費用包括挂号費、檢查費等,一般在1000-2000元不等。
2.檢查費用:幹細胞腎髒移植前的檢查費用較高,主要包括血液、尿液、影像學等檢查,費用大約在5000-10000元。
3.移植費用:幹細胞腎髒移植的費用相對較高,主要包括幹細胞培養、移植手術、術後治療等費用,費用大約在10-20萬元人民币。
4.術後康複費用:術後康複費用包括藥物、複查等費用,一般在1-2萬元人民币。
綜合來看,幹細胞腎髒移植的總費用大約在12-23萬元人民币左右,具體費用還需根據患者的具體情況和醫院收費标準來确定。
二、幹細胞腎髒移植流程解析
1.初診:患者到院後,首先進行挂号、問診,了解患者的基本病情。
2.檢查:根據患者的病情,醫生會安排一系列檢查,包括血液、尿液、影像學等檢查,以評估患者是否符合幹細胞腎髒移植的适應症。
3.制定方案:根據檢查結果,醫生會制定個性化的幹細胞腎髒移植方案。
4.幹細胞培養:提取患者或供體的幹細胞,進行體外培養、擴增。
5.幹細胞移植:将培養好的幹細胞通過導管注入患者腎髒,修複受損的腎髒功能。
6.術後治療:術後患者需進行抗排斥、抗感染等治療,同時密切觀察病情變化。
7.複查:術後定期進行複查,評估移植效果。
幹細胞腎髒移植作爲一種新興的腎髒修複技術,具有創傷小、恢複快、療效顯著等優點,爲衆多腎髒疾病患者帶來了新的希望。然而,患者在選擇幹細胞腎髒移植時,還需綜合考慮費用、醫院實力、醫生經驗等因素,以确保手術的成功率。
-
上一頁: 亳州幹細胞價格報告,治療費用一覽?
-
下一頁: 自身幹細胞移植全面費用解析與對比。
- 2024-10-15打幹細胞可以提高免疫力嗎,注射幹細胞的好處及價格參考
- 2024-12-04幹細胞治療腎腫瘤費用大概是多少,有哪些影響因素
- 2024-11-09上海幹細胞治療費用是多少,如何評估幹細胞醫院性價比
- 2024-11-13醫院推薦做幹細胞移植多少錢一次
- 2024-07-22幹細胞移植費用,幹細胞移植成功率高嗎
- 2024-09-05西南醫院幹細胞移植技術怎麽樣多少錢
- 2024-09-13興平幹細胞存儲公司有幾家,儲存費用是多少
- 2024-09-03多能幹細胞研究進展,多能幹細胞的作用和功效
- 2024-09-10幹細胞技術應用到眼角膜移植時,優勢在哪裏
- 2024-09-04幹細胞制備新技術的優勢及應用前景
- 2024-09-16幹細胞技術高度近視能恢複嗎
- 2024-09-27韓城幹細胞存儲機構哪家信譽高?如何選擇?
- 2024-09-01廣州幹細胞存儲多少錢一年,不同類型細胞存儲費用
- 2024-09-17幹細胞采集存儲流程費用
- 2024-08-30牙髓幹細胞功效,牙髓幹細胞療法四大優勢
- 2024-09-07幹細胞療法上市藥物有哪些
- 2024-10-11如何推廣幹細胞存儲業務?有哪些高效策略?
- 2024-09-13幹細胞在抗衰老領域中的應用方向盤點
